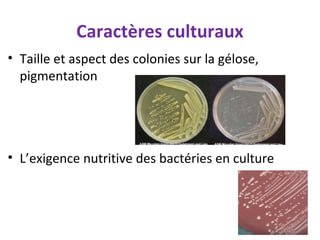
Caractères culturaux
• Taille et aspect des colonies sur la gélose,
  pigmentation




• L’exigence nutritive des bactéries en culture
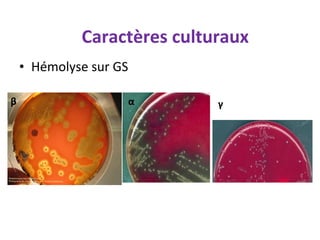
Caractères culturaux
    • Hémolyse sur GS

β                   α        γ

Le document décrit les méthodes d'identification bactérienne à partir de cultures, incluant l'analyse morphologique, culturale et biochimique. Il détaille également la réalisation d'un antibiogramme pour évaluer la sensibilité des bactéries aux antibiotiques, ainsi que les tests de résistance. Des démonstrations pratiques sont également prévues pour illustrer les techniques de laboratoire utilisées.